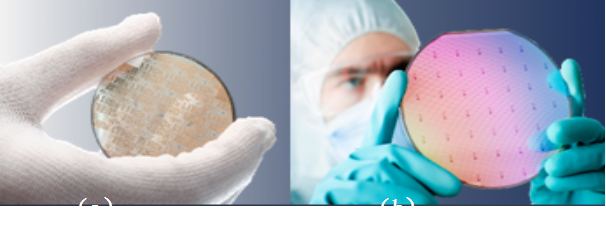

硅光PID帮助运营商构建最具性价比的网络架构
波分网络作为承载网具备大带宽、低时延、硬管道等优点,但传统波分技术使用复杂光层来支持多波道数据承载,这适合大容量、少站点的骨干网和城域核心,但在小容量、多站点的城域及接入场景,却意味着复杂的光层调测和运维,光子集成器件(PID)技术的发展可以很好地解决这一困境,其采用光层器件与电层芯片耦合技术,无外部光层,也无需光层调测,提供类似SDH的简单运维。

图1 硅光PID极大简化网络设备
硅光PID技术已经实现80KM跨距内无需光放,外部无需色散补偿模块,并已实现单槽位400G,这意味着实现单环800G容量也仅需两块单板。扩容时,在核心层直接扩展波道,在汇聚层增加PID单板,即插即用,非常方便。如图1所示,采用硅光PID技术可以极大简化网络设备,以一个单槽位400G的PID为例,如果原先采用10×40GOTU单板,那么直接节省90%槽位,此外还省掉MUX、DEMUX和DCM模块,由此可以节省整个机房50%空间,节省单板功耗50%,节省光层备件50%,节省连纤50%。此外,由于硅光PID系统只需安装PID单板和连接少量跳线,因此比原先波分系统节省工时节约40%。
基于硅光PID技术的城域网络在设备功耗和集成度上的具大技术优势,实现了光层极简,帮助运营商实现最具性价比的网络架构。硅光PID一经商用,助力4K视频让超宽带价值得到了释放,实现了消费者、运营商和4K内容提供商三方受益,形成了超宽带的商业正循环,一举解决了传统承载网在4K视频业务快速发展下面临光纤资源耗尽和光纤铺设周期长的双重挑战,构建了大带宽、低时延、零丢包和易运维的极简网络架构,完美匹配4K承载要求。
PID技术的三大典型优势
PID技术采用硅光子集成技术,利用统一的CMOS工艺平台,一举突破早期PID在集成度、性价比和功耗的诸多瓶颈,具体如下:
(1)高集成度
目前,PID技术除了硅光子集成,还有二氧化硅平面光波导(SiO2-PLC),III-IV族材料(如InP)单片集成。相比其他二者,硅光PID的集成度最高,主要体现在其器件体积最小,因而同样的空间可以容纳几倍的器件规模。

图2 硅光与其他工艺下AWG波导尺寸对比
集成光器件中,波导的尺寸占据整体器件尺寸的大部分,而波导波导芯层材料与波导包层材料的折射率差直接影响波导的弯曲半径,折射率差越大,弯曲半径越小,则器件尺寸越小。硅光波导的折射率差是目前所有商用光波导中最大的,因此能够实现极小的器件尺寸。如图2所示,对于阵列波导光栅(AWG)而言,在二氧化硅平台下,面积为平方厘米量级;而在硅光平台下,却只有前者的千分之一。
(2)高性价比
除了集成度,硅光PID技术在性价比上具有极大的优势。

图3 (a)传统手工校对光器件 (b)CMOS规模化自动化生产
首先,传统的光器件,其采用不同的材料来实现不同功能,各种材料对应生产工艺不同,因此一个器件的生产涉及众多环节;此外,传统分立器件装配大量依靠手工调试和校验,生产效率低,因此导致光器件价格居高不下。硅光PID技术可以利用硅基制备除光源外的各种光功能器件,即通过单一工艺流程实现整个器件的制备,并利用了现有成熟的微电子加工工艺(CMOS工艺)实现规模化、自动化生产,避免了产线重复投资,有利于降低相关投资。图3展示了传统光器件生产和硅光CMOS自动化工艺之间的对比。
图4 (a)InP晶圆 (b)硅基晶圆
图4所示为InP材料和硅基材料的晶圆尺寸对比,显然受到材料制备特性的限制,传统III-IV族光电器件仅能够在3-4英寸晶圆上面实现,而硅光器件却能够在8-12英寸晶圆上面一次加工,且硅光芯片尺寸更小,因此能够在一次加工中得到更多的芯片,也使得生产单个硅光芯片的费用远低于传统光电芯片。
(3)低功耗

图5 (a)InP晶圆 (b)硅基晶圆
相比传统技术, 硅光PID技术在功耗上占据极大优势。传统光器件由多种材料组成不同的功能器件,如图5(a)所示为一个普通的发射机结构,激光器、调制器和连接波导分别用InP、LiNbO3和SiO2三种不同材料制成。各功能器件连接处由于材料的晶格结构不同,导致晶格失配,接触界面不连续有缺陷,光在其中传播就会产生散射而损耗;此外,由于不同材料折射率不同,光在介质间传播也会导致不同程度的反射和折射,也产生一部分损失。图5(b)显示了光信号在传统器件不同材料中传播损耗的示意图。而硅光PID技术由于统一工艺材料,所以器件内部没有多材料导致的光损耗,因此为了获得与传统器件同样的输出功率,其光源的发射功率要低很多,因此模块的功耗也相应降低了。
可以预见,高清视频将成为未来互联网流量的主宰,作为承载网络,面对超大带宽视频数据和最终用户体验要求,硅光PID通过多通道集成技术实现数据管道的大规模扩容,确保未来传输流量的几何量级提升保障。此外,硅光PID技术以极简架构回归刚性硬管道,剔除网络QoS损失,以绝佳的高可靠性、低时延为客户带来极佳视频业务体验。(文章来源:C114中国通信网)

